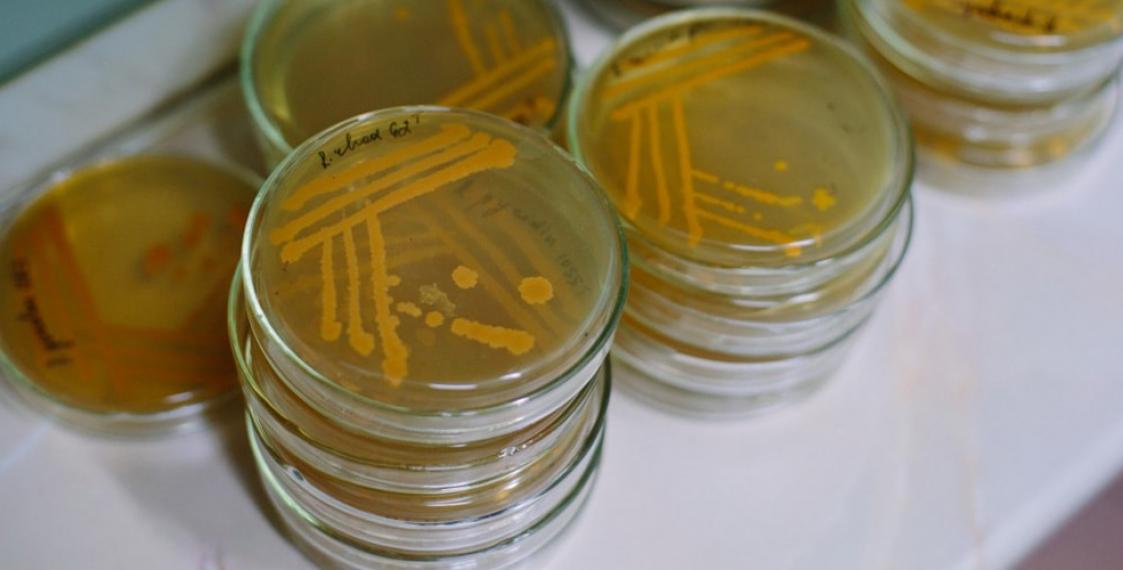

Классным руководителям в Минске приказали собирать у учеников анализы кала
Ливянта это возмущает.
"Каждый день тысячи детей сдают анализы в поликлиниках — и в связи с болезнью, и для получения справки. Предлагаю включить этот мониторинг в обязательные анализы. Это же очевидное и простое решение. В поликлиниках же есть специалисты и специальные места для хранения анализов".
Твит по теме
Заметили ошибку? Пожалуйста, выделите её и нажмите Ctrl+Enter










